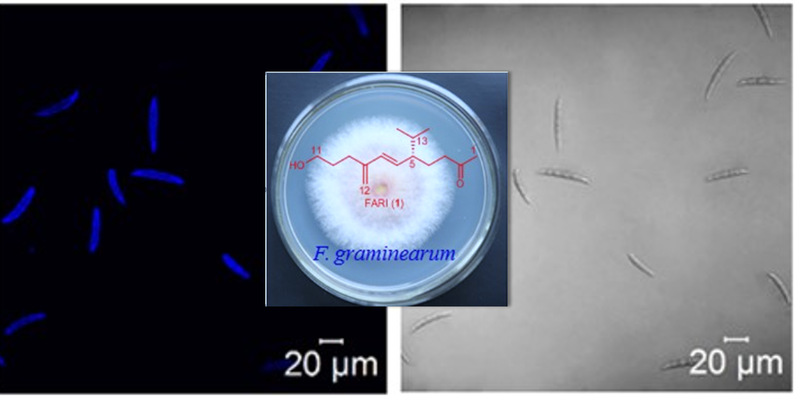

A research team led by Professor QI Jianhua has published a research paper entitled “Identification of an Asexual Reproduction Inducer of Phytopathogenic and Toxigenic Fusarium” in Angewandte Chemie International Edition, a top journal in chemistry. This paper was highly spoken of by two reviewers, which was rarely seen according to the editor. The research has laid an important foundation for the development of specific antibiotics and antimicrobials.
The discovery of hormones (or pheromones) of animals, plants and microorganisms has always been one of the most important and difficult research subjects. In the previous study of sexual reproduction pheromone, 1.2 mg sexual reproduction pheromone (hormone alpha 1) was isolated successfully from 1800 L culture broths of Phytophthora and the structure of alpha 1 was determined by Prof. QI Jianhua and his collaborators (Qi et al, Science, 309: 1828, 2005; Yajima et al, Nat. Chem. Biol., 4 (4): 235, 2008). Then, the structure of hormone alpha 2 was determined (Ojika et al, Nat. Chem. Biol., 7: 591, 2011). These discoveries provided an important target for the effective control of Phytophthora.
Since joining ZJU in 2008, Prof. QI’s group has been working on asexual reproduction hormone of microorganisms. In this research, one asexual reproduction hormone, Fusarium asexual reproduction inducer (FARI), was isolated from the culture broths of Fusarium graminearum successfully, which exhibited conidium-inducing activity at an extremely low dose (1 ng). The structure of the hormone was determined by spectroscopic analysis, total synthesis, and conidium–inducing assays of synthetic isomers. The universality of FARI among Fusarium species has also been discovered.
This study suggests that asexual reproduction of Fusarium (possibly including other all microorganisms) is regulated by hormones or hormone-like signal molecules. FARI exhibits high stereo-selection and changes of the stereostructure of the chiral center led to the completely loss of conidium-inducing activity.
The research was supported by the National Natural Science Foundation of China. Prof. QI Jianhua is the corresponding author of this study, and this study was mainly carried out by two Ph. D. students, CHENG Lihong and SUN Yujuan, under the supervision of Prof. QI. In addition, Dr. XIANG Lan from ZJU’s College of Pharmaceutical Sciences and Prof. Toshio Nishikawa from Nagoya University are co-corresponding authors of the paper. Co-authors also include Prof. MA Zhonghua from the Institute of Biotechnology.
People

QI Jianhua
Professor, College of Pharmaceutical Sciences